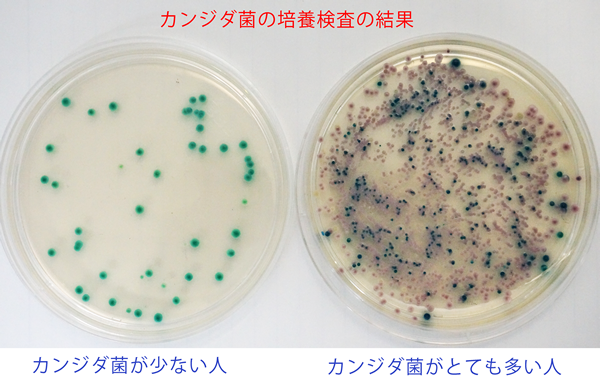

|
||||||||||||||||||
むし歯や何らかの原因で欠けてしまった歯の修復、および歯の痛みを取り除く治療です。 欠損した範囲や深さ、歯の神経まで感染が及んでいるかで、治療内容や回数、修復物によって費用が異なります。 |
||||||||||||||||||
|
||||||||||||||||||
●むし歯治療 (う蝕治療) 『歯が欠けた』『詰め物が外れた』『欠けたところが痛い』などの症状を治療します。 むし歯が深い場合は、むし歯の底の歯の表面を強化する薬を入れて様子をみるなど、なるべく神経を温存するように努めております。 また、歯の溝がむし歯になりそうな場合、予防として溝を塞ぐ治療やむし歯を予防するフッ素の塗布も行っております。 ●根管治療 むし歯が深く、どうしようもなく歯の神経を取る治療や歯の神経の管から根の先に感染を起こした歯の消毒を行う治療です。 必要に応じて、高精細なCT画像で診断し、Ni‐Tiロータリーファイルを用いて治療します。 症状によって、回数がかかることがあります。 ●知覚過敏処置 むし歯以外で、冷たい物や歯ブラシが当たって歯が凍みる『象牙質知覚過敏』と呼ばれる症状があります。 歯ぎしりや過度なブラッシング圧で、歯の表面の結晶が崩れ、そこを冷たいものが触れると、歯の神経が疼痛を覚える状態に陥ります。 通常、凍み止めの薬を歯面に塗布したり、凍み止めの成分を含む歯磨き粉を使用することで、症状が緩和されます。 しかし、知覚過敏自体が、歯の神経のSOSとして現れることがあり、神経を取らないと改善しない場合もあります。 ●歯冠修復処置 むし歯による欠損や歯の破折部などを修復する治療です。 軽度の場合、コンポジットレジン(CR)という歯の色と近似した樹脂を直接詰めます。 複雑な欠損の場合、型取りをして、後日装着するようになります。 欠損の大きさから部分的な詰め物(インレー)や歯の全体を覆う被せ物(クラウン)、歯の欠損部を補うブリッジで対応します。 保険適応の白い被せ物・詰め物を積極的に用いており、保険適応になったCADCAMインレー・クラウンでの修復も行っております。 |
||||||||||||||||||
|
||||||||||||||||||
|
||||||||||||||||||
歯を支える骨や歯茎を歯周組織といいます。 細菌や嚙み合わせ等による歯周組織に破壊が起こったものを歯周病といいます。 歯周病細菌は歯肉に付着すると増殖しながら、歯垢(プラーク)を形成し、周り破壊し、より細菌が住みやすい環境を整えていきます。 歯周ポケットを底へ底へと進行し、歯茎の腫れや出血、歯がぐらぐら動くようになり、ひどい状態になると抜歯に至るケースもあります。 また、歯や口の中だけの問題ではなく、糖尿病や認知症など、全身の健康にまで悪影響をあたえる疾患です。 |
||||||||||||||||||
![]() |
![]() |
|||||||||||||||||
| ●歯周病治療 歯の表面に付着した歯石や不良な被せ物の除去を行い、歯の動揺を招く嚙み合わせの調整を行い、歯茎の安定化を図ります。 また、歯周病の治療や予防には、歯周ポケット内の細菌の種類や構成分布を把握することが重要です。
歯周病の治療には、徹底した除菌と歯周病を進行させる原因の除去が必要で、それを継続することが重要になります。 歯周病は進行すると、なかなか治りにくい病気が、患者さんのセルフコントロールと歯科医院での定期的なケアで、進行を防ぐことができます。 ●レーザー治療 当院では、オサダ社の半導体レーザーを使用しております。 半導体レーザーは、歯周組織のダメージを最小限に抑え、歯周ポケット内の殺菌、清掃効果があり、ポケット内の粘膜の修復に効果があります。 歯周ポケットの深さの減少と炎症の消退が望めます。 ※当院のレーザーは、無麻酔のむし歯治療に対応しておりません。 |
||||||||||||||||||
|
||||||||||||||||||
| 口腔外科治療 ●顎関節症治療 『顎が開きにくい』『開ける時に痛い』『カクンと音がする』などの顎関節の症状の治療です。 顎関節症は、あごの骨のすり減りや関節軟骨のズレ、顔面の筋肉痛など、さまざまな症状があり、顎骨の変形をきたす場合があります。 高周波治療やマウスピースの製作を行います。 ●口腔外科処置 親知らず(埋伏智歯)等の抜歯や顎骨内の膿の袋の摘出などを行います。 また、歯の移植や再植も積極的に行っております。(一部保険適応です。) ただし、抜歯や重度の全身疾患をお持ちの患者さんの場合、高松赤十字病院口腔外科を紹介させていただく場合があります。 |
||||||||||||||||||
| ●口腔粘膜処置 口内炎やヘルペス、舌痛症、口腔乾燥症などの口腔粘膜の疾患に対処します。 金属アレルギーが疑われるの場合、皮膚科でのアレルギー検査を紹介させていただきます。 なかなか治らない口内炎は、口腔がんの初期の可能性もありますので、放置せずご相談ください。 |
||||||||||||||||||
|
||||||||||||||||||
| 義歯 当院では、院内技工室を併設しており、外注に依存しないため、スムーズで、ニーズに合わせた義歯の製作を行っております。 3Dプリンタを活用しており、入れ歯のバネから金属床義歯の設計など、より複雑な設計も短期間で製作可能です。 人工の歯は、歯科医師が並べており、嚙み合わせにこだわって製作しています。 また、院内に歯科技工士も勤務しておりますので、義歯の修理も迅速に対応しております。 |
||||||||||||||||||
![]() |
||||||||||||||||||
●金属床義歯(自由診療) 一部に金属を使用する義歯で、粘膜にふれる部分をピンクのプラスチックから金属に置き換えることで、装着感が格段に向上します。 保険の入れ歯では、強度の関係で舌が触れる部分がどうしても分厚くなってしまいます。 その部分を金属に置き換えることで、薄くて、しゃべりやすく、異物感が軽減でき、その強度から壊れにくくなります。 食べ物や飲み物の熱を粘膜に素早く伝導させるので、お口の火傷を防ぐことに結びつきます。 |
||||||||||||||||||
●コーヌス義歯(自由診療) コーヌス義歯は、金属床義歯とブリッジの良いところを掛け合わせた、ドイツ発祥の義歯です。 残存する歯に内冠という被せ物を施し、それに合わせた外冠でキャップする茶筒の原理を利用した義歯です。 歯を覆うようにして義歯を安定させるため、バネを用いないため、審美性に優れます。 非常に優れた安定性から咀嚼しやすく、取り外しができることから、歯の清掃性に優れています。
|
||||||||||||||||||
|
||||||||||||||||||
| ●オーラルフレイル予防 オーラルフレイルとは、加齢に伴い、歯の喪失や硬いものが噛めないなどの咀嚼機能の低下からはじまり、飲み込み機能(嚥下機能)の低下へと連鎖。 さらに悪化すると咀嚼障害や嚥下障害による栄養不足から心身の機能低下へ進行する『口からはじまる身体の衰退』です。 歯周病の治療や入れ歯の製作で噛めるにする一方で、口に関する“ささいな衰え”を早期に発見するため、滑舌や飲み込み、咀嚼能力検査を行います。 オーラルフレイルが疑われる場合、口腔機能向上のための口や舌の運動指導を行います。 |
||||||||||||||||||
![]() |
||||||||||||||||||
; |
||||||||||||||||||
| ●ホワイトニング 薬剤を用いて、歯の表面を白くしていく治療です。 お家で行う方法(ホームホワイトニング)と歯科医院で行う方法(オフィスホワイトニング)に2パターンがあります。 |
||||||||||||||||||
![]() |
||||||||||||||||||
ホームホワイトニングは、回数や手間がかかりますが、じっくり白くしていくため、色の後戻りがオフィスに比べてゆっくりだと言われております。 また、薬剤の濃度もホームの方が弱いため、歯の凍みもホームの方が軽いです。 当医院では、まずホームホワイトニングからお試しいただいて、必要に応じて、オフィスホワイトニングを併用することが多いです。 ホワイトニング中は、歯の黄ばみの原因となるカレーやコーヒーなどの飲食はお控えください。 ●PMTC 歯みがきで取れない歯の着色は、歯ブラシの毛先の繊維より圧倒的に細かい歯の表面の溝に潜んでいます。 PMTCとは、歯科医院で機械を用いた歯のクリーニングで、取りきれなかった歯の汚れや茶渋を除去し、歯の表面をツルツルにします。 また、『着色を取り除く 』『歯の凍みを軽減する』『歯の細かい傷を修復する』『歯周病対策』などの目的に応じたペーストを使い分けております。 ●審美歯科 簡単な矯正治療や保険治療で用いない白い被せものを装着することで、口元の審美性を高める治療です。 自費診療で用いる被せ物や詰め物に用いる素材は、E-maxやジルコニアなど、審美性と強度を兼ね備えた材料を用い、院内で製作します。 ※当院は、歯科矯正を専門としておりませんので、難しいケースは、矯正専門歯科医を紹介させていただきます。 |
||||||||||||||||||
|
||||||||||||||||||
| ●口臭測定 歯周病の進行や歯や舌の汚れなど、口が原因の口臭、蓄膿症による鼻腔や胃腸や糖尿病が原因の口臭があります。 当院では、口臭の原因となるガスの濃度を測定するオーラクロマを導入しております。 呼気中に含まれる揮発性硫黄化合物を口臭原因の三要素(硫化水素・メチルメルカプタン・ジメチルサルファイド)に分類。 それぞれのガスに対して濃度を表示され、それらが人間の嗅覚に感じるレベルの臭いである判別します。 |
||||||||||||||||||
![]() |
||||||||||||||||||
| また、唾液の量が減少するすると口臭が強くなりますので、必要に応じて、唾液量の検査も行います。 口臭測定を受診したい患者さんは、オーラクロマの準備がありますので、事前にご連絡よろしくお願いします。 また、検査前に下記の点にご注意ください。 |
||||||||||||||||||
| ●ポイックウォーター ポイックウォーターは、超純水と塩を電気分解して生成された、タンパク質分解型洗浄水です。 殺菌能力が高く、細菌やウイルスに有効ですが、薬品を用いていないため、安心使用いただけます。 歯周病や口臭の予防に効果がありますので、お家での口腔ケアにご使用ください。 |
||||||||||||||||||
|
||||||||||||||||||
子どものむし歯は減少傾向にありますが、むし歯以外にもお子さんのお口のトラブルはたくさんあります。 歯の生え変わり、転倒して歯をぶつけた、指しゃぶりがやめられない・・・などなど。 歯並びは、単なる見かけだけの問題ではなく、大人になって歯周病や顎関節症の発症に大きく関わります。 また、近年問題視されているのが、お口が未発達で、くちびるや舌の筋力が弱いお子さんが増えています。 具体的には、食べるのが周りの子とより極端に遅かったり、いつもお口がぽかーんと開いていたり、タ行の発音が上手できないなどがあります。 当院では、お口の中だけではなく、親御さんが家庭内で見守ってほしい点もアドバイスさせていただきます。 ※当院は矯正専門ではありませんので、複雑な矯正治療が必要な場合は、矯正歯科専門医を紹介させていただきます。 |
||||||||||||||||||
![]() |
![]() ![]() |
![]() |
||||||||||||||||
![]() |
||||||||||||||||||
m(__)m ごめんなさい、こちら只今準備中ですm(__)m 谷口歯科医院でしか受けれない予防歯科プログラムを準備しております。 ただ、口内フローラのゲノム研究から生まれた谷口歯科医院オリジナルの歯磨きジェルをつくりました! プロポリスを高濃度に配合しており、味も親しみやすいシトラスミントです! プロポリスには、抗菌作用、抗酸化作用、抗炎症作用があることから、歯周病だけでなく、口内炎にも一定の効果があります。 ![]() |
||||||||||||||||||
|
||||||||||||||||||
| 細菌検査 むし歯や歯周病は歯や歯周組織の細菌感染による疾患で、口腔と細菌の関係は切っても切れない関係にあります。 谷口歯科医院では、併設の口腔常在微生物叢解析センターで、さまざまな口腔微生物の検査、解析を行っています。 また、患者さんのお口から採取した生きた細菌をモニターで観察する位相差顕微鏡検査も行っております。 ●メタゲノム解析 5,6種類の特定の細菌しか検出できなかった昔の検査(リアルタイムPCR)と比較して メタゲノム解析100種を超える菌種とその割合新しい検査 |
||||||||||||||||||
![]() |
||||||||||||||||||
例えば、従来のリアルタイムPCRでは、トレポネーマ属であればデンティコーラ菌しか検出できませんでした。 しかし、メタゲノム解析では、その他のトレポネーマ属の細菌も検出することができます。 そして、どのような細菌が、その環境下で幅を利かせているを判断することです。 |
||||||||||||||||||
リアルタイムPCRと比べて遥かに解析費用がかかるメタゲノム解析ですが、谷口歯科医院ではリアルタイムPCR程の費用で解析を実施しています。 ●カンジダ検査 カンジダとは、口の内に生息するカビ(真菌)で、口内が不潔であったり、免疫力の低下、医薬品の使用によって増加することがあります。 唾液中のカンジダ菌を培養法にて検出しています。 培養法を用いているためカンジダ菌の数を数字で表すことができ、治療の効果を客観的に判定できます。 |
||||||||||||||||||
![]() |
||||||||||||||||||
唾液をカンジダ用培地で培養した結果です。一つ一つの粒々がカンジダ菌のコロニーです。 シャーレが埋め尽くされるほど、多く検出される人もいます。 カンジダが多い場合、舌の清掃指導や抗真菌薬の投与を行います。 ※来院できない方のお電話でのお問い合わせはお断りしております。 遠方にお住まいの口腔内細菌等がどうしても気になる方は、大変申し訳ございませんが、歯学部がある大学等にお尋ねください。 |
||||||||||||||||||
|
||||||||||||||||||
| インプラント治療 歯を失った部位に人工の歯根を埋入し、それに被せ物を施し、噛めるようにします。 ブリッジのように前後の歯を削ることがなく、入れ歯の煩わしさもない、よく自然な噛み心地を取り戻すことができます。 当院は、国産で信頼性が高い京セラのインプラントを用いております。 高精細CTと口腔内スキャナーで得られた3D画像をマッチングし、インプラント埋入から最終的な嚙み合わせまでをプランニングします。 CADCAMで埋入ガイドを製作し、位置のズレがない正確な埋入を行っています。 また、必要に応じて、骨造成も行います。 |
||||||||||||||||||
|
||||||||||||||||||
◎インプラント埋入から被せ物が入るまでのながれ◎ ![]() |
||||||||||||||||||
|
||||||||||||||||||
睡眠と歯科 ●睡眠時無呼吸症候群 睡眠時無呼吸症候群は、睡眠中に呼吸が止まる、または浅くなる病気です。 高血圧、脳卒中、心筋梗塞などを引き起こす危険性が約3~4倍高くなるとされています。 また、日中の眠気から作業骨率の低下、 居眠り運転や労働災害の原因に関与します。 国内に約500万人の罹患者がいるとされていますが、実際に治療を受けている患者さんは、10%と、早期発見が困難な疾患です。 当院が導入した歯科用CTは、広範囲を低侵襲で撮影でき、気道形態を解析、その閉塞を検知できます。 当院と連携している内科を紹介させていただき、睡眠時無呼吸の診断がされた場合、必要に応じ、気道を確保するための装置を製作します。 |
||||||||||||||||||
|
||||||||||||||||||
●歯ぎしり防止装置製作 歯ぎしりは、あごの悪習癖の一つですが、睡眠時に行っているため、自制できるものではありません。 『歯ぎしりの音』や歯の摩耗だけでなく、『歯並びへの影響』、『歯が破折』、『顎関節症』の原因に結び付くため、放置すべきではありません。 日中はあごに力が入らないように気をつけると同時に、睡眠時の歯ぎしり防止装置(ナイトガード)を装着します。 歯を守るだけでなく、肩こりが軽減することもあります。 下のような症状がある方は、歯ぎしりやくいしばりをしていることが考えられます。 |
||||||||||||||||||
|
||||||||||||||||||
ホームに戻る
谷口歯科医院 〒760-0054 香川県高松市常磐町1丁目9-14 TEL 087-831-8020 FAX 087-831-8021






.jpg)

.jpg)
;